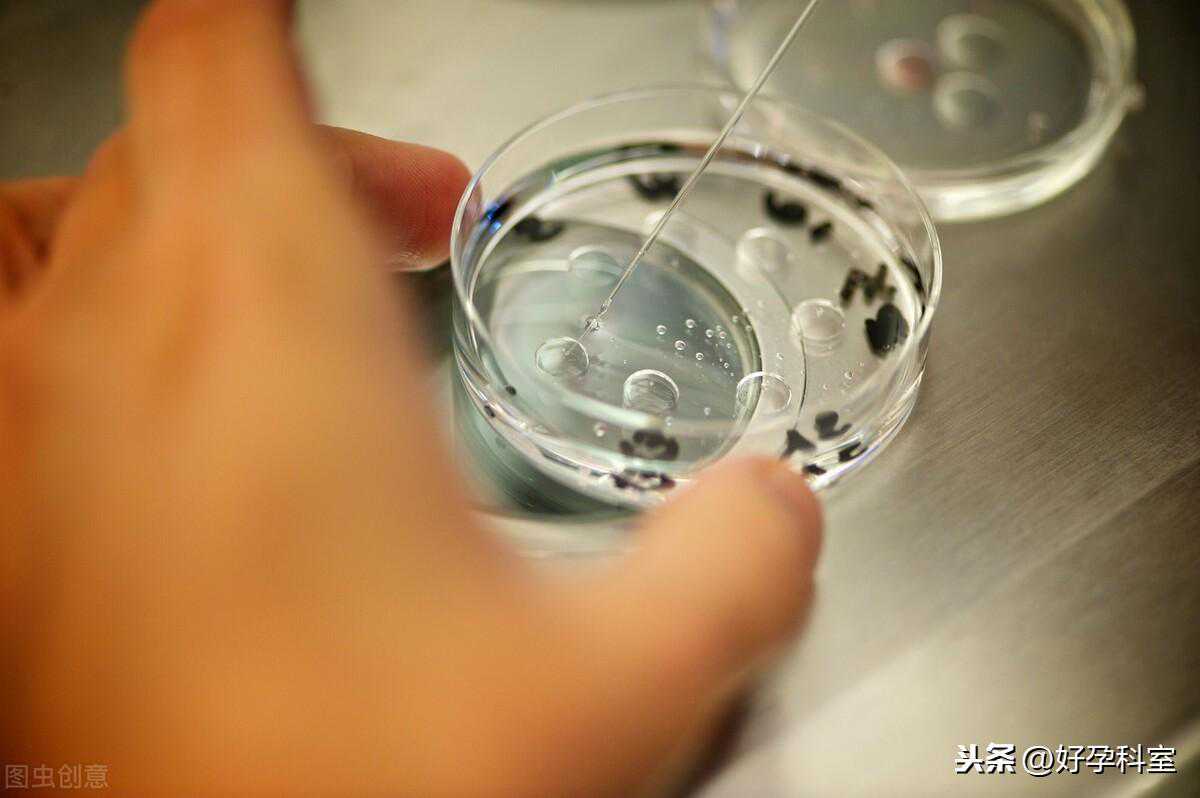

在试管婴儿周期中,患者促排至卵泡大小合适时就打破卵针,34-36小时后取卵,之后加精子受精,再培养胚胎,一般要走过这几个阶段:

第一阶段,是受精卵的阶段,就是卵子和精子培养在一起的24个小时,我们可以看到两个原核,男性的雄原核和女性的雌原核,是在精子与卵子受精卵约16-18小时后。
第二阶段,卵裂期是胎儿分裂的阶段,这个时期是卵子和精子培养后的时期,胚胎将在24-72小时内从1个细胞分裂为2个细胞,分成4个细胞,6个细胞和8个细胞,直到细胞数量继续增加。通过显微镜可以看出,还有更多的划分,并且它们一起形成了一个称为“致密桑椹胚”的组合。好的致密桑椹胚应该有16-32个细胞。
第三阶段,是囊胚或胚泡,就是做单精子注射后胚胎长大到5-6天,是合适胚胎着床的阶段,然后分裂成大概80-120个细胞。因此,囊胚能分裂成两个细胞。内细胞团群是细胞长大成胚胎,然后在子宫着床;滋养外胚层是细胞长大成胎盘并在子宫内膜附着。
成功培养胚胎后,选择胚胎移植阶段通常这样做:
试管婴儿移植的胚胎会有两个阶段,就是其卵裂和胚泡,但是现在没有研究确定哪个阶段是最成功的。
但是通过物理特性来解释囊胚期,外观更适合植入。同样,分裂阶段是胚胎在输卵管中的时候,可能尚未准备好移植,要等到胚胎长大成卵裂才准备好移植入子宫。此外,卵裂的胚胎有机会在移植之前停止增长,因此将囊胚移植进子宫,很多医生认为是非常可取的。

一般来讲,医生会将精卵结合的这天定为第零天,零天做单精注射还需要进行以下各种生长检查。
第1天:16到20个小时之内,将检查是否有原核,如果有就是表现它们已经受精卵了。
第3天:卵裂阶段,24个小时后到4天将检查胚胎是否分裂好细胞,平常应该有超过8个细胞。在这个时段内,如果发现胚胎不长大,医生将会穿透胚壳,以帮助胚胎从饲养的试剂中获取更多营养。这是使外壳变薄以使胚胎更容易孵化的过程。此外,有助于容易拉动胚胎的一个小细胞进行遗传分析。
第5-6天:囊胚阶段是受精120个小时以后,将检查胚胎是否健康,还有胚胎分级,然后选最健康的胚胎移植到子宫内膜里。

最后,胚胎培养是一项微妙的工作,为了使胚胎能够生长并准备在最合适的时期移回子宫,应采用各种方法和技术来照管胚胎,所有这些因素都会影响试管的成功。
声明:以上内容由「好孕科室」原创,未经授权禁止转载,相关不孕不育、试管婴儿观点仅供健康参考,关于病情实际情况,与医生当面讨论为准,不能替代医生的面对面诊断,请知悉!